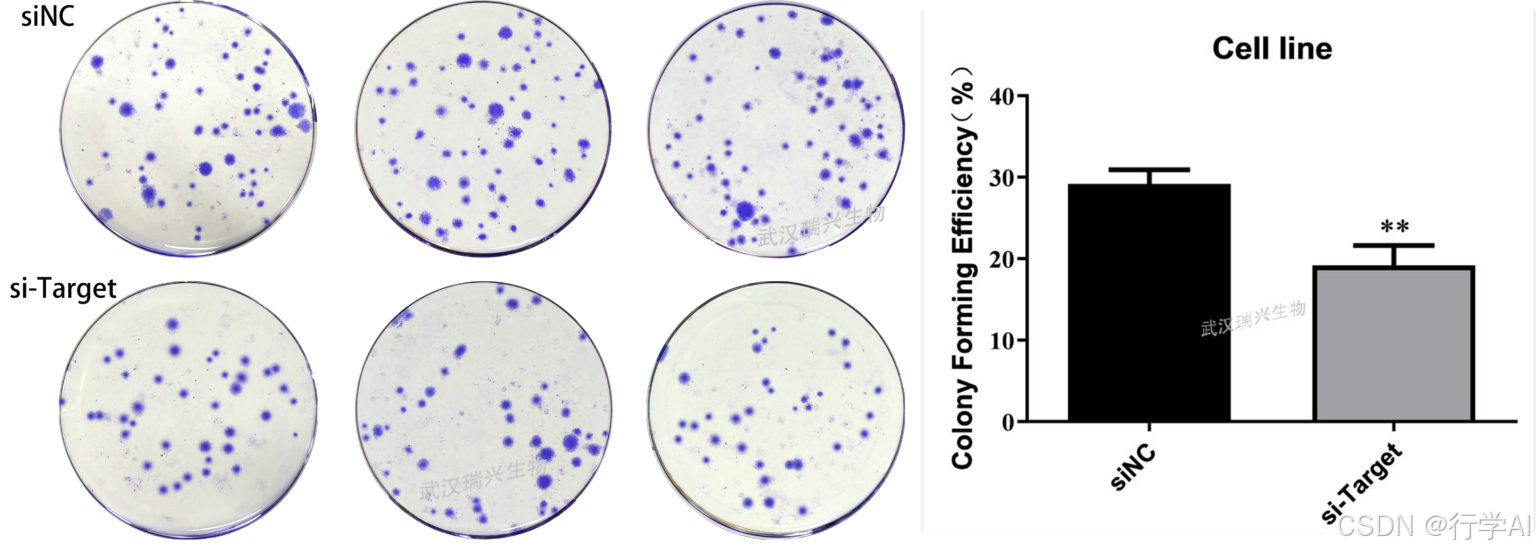

肿瘤,这个让人闻之色变的词汇,一直是医学领域的重大挑战这是每个医学研究生都绕不开的研究内容,你有可能不直接研究肿瘤相关内容,但是或多或少都听说过。其中,肿瘤增殖是肿瘤发展过程中的关键环节。肿瘤增殖是指肿瘤细胞数量不断增加的过程。正常细胞的生长和分裂受到严格的调控,而肿瘤细胞则摆脱了这些控制机制,具有无限增殖的能力。肿瘤细胞的增殖速度通常比正常细胞快得多,这使得肿瘤能够迅速生长并侵犯周围组织。那作为一个如此重要的研究内容,我们可以通过哪些手段来对其进行研究呢,不妨来问问行学AI。
我们在行学AI中输入“介绍一下肿瘤增殖以及相关实验”

我们可以看到行学AI给出的答案,我们可以将其概括一下,可以大致分为表型研究和机制研究。其中表型研究可以大致理解为探究肿瘤细胞的增殖能力的强弱,机制研究则可以大致理解为探究肿瘤细胞无线增殖的原因。那么今天让我们来探讨一下肿瘤细胞增殖的表型研究。
首先,我们来看看MTT或CCK8这类酶促反应的细胞增殖实验。因为CCK-8实验相较与MTT实验毒性更低更准确,我们就直接介绍CCK-8实验。接下来我们在行学AI中输入“介绍一下CCK-8及其相关实验方案”

我们可以看到行学AI给出的结果:CCK-8实验是将活细胞具的代谢活性转化为反应液的光密度(OD值),进而可以推算出细胞的数量或细胞生长的情况。其步骤也包括细胞培养、加入CCK-8、孵育和测量。这是一张CCK8的结果图,第一次看的小白可能看不懂,我们也可以借助AI解读一下。我们将这张图导入进AI并输入“这是一张CCK8的结果图,帮我解释一下”


我们可以看到AI给出的解释:纵轴是相对细胞增殖,横轴是时间(0 - 80 小时)。
图例有三组:对照组(Control (PBS))、MALAT1 - siRNA 处理组、MALAT1 - scramble 处理组。
结果:对照组细胞增殖逐渐增加;MALAT1 - siRNA 处理组初期略高,但 40 - 60 小时显著下降;MALAT1 - scramble 处理组与对照组增长趋势相似。图B与图 A 类似,MALAT1 - siRNA 处理组在 40 - 60 小时细胞增殖显著下降,MALAT1 - scramble 处理组与对照组增长趋势相似。
因此可以证明在两种细胞系中,MALAT1 - siRNA 处理在 40 - 60 小时抑制细胞增殖。
克隆形成实验也是一个验证肿瘤细胞增殖的重要实验。克隆形成实验是一种用于评估细胞在特定条件下的生存能力和增殖能力的实验技术,以确定细胞的克隆形成能力。其原理单个细胞在适宜条件下能够存活、增殖,并形成一个细胞群体(或“克隆”)。通过培养一定数量的细胞,可以观察到每个细胞所形成的克隆的数量。克隆的形成能力通常反映了细胞的增殖能力及其对外部环境的适应性。我们在行学AI中输入“介绍一下克隆形成实验的实验步骤”,下面是行学AI给出的克隆形成的实验方案:
同样的,我们还是找一张结果图来给大家解读一下。将这张图导入AI后输入“这是一张克隆形成实验的结果图,帮我解读一下”
我们可以看到图的左侧展示了两组细胞培养皿中的克隆情况:
“siNC” 组是非靶向 siRNA 对照组,培养皿中蓝色克隆点较多且密集。
“si - Target” 组是靶向特定基因的 siRNA 处理组,培养皿中蓝色克隆点较少且稀疏。
图的右侧是柱状图:
纵轴是克隆形成效率(CFE),以百分比表示,范围从 0 到 40%。
横轴是处理组(siNC 和 si - Target)。
“siNC” 组的克隆形成效率约为 30%,“si - Target” 组约为 10%,且两组存在显著差异,这表明靶向特定基因的 siRNA 处理降低了细胞的克隆形成效率,该基因可能对细胞增殖有重要作用。
同时,为了研究肿瘤细胞的增殖,细胞实验是远远不够的,大多数实验还是要涉及体内,因此我们会选择动物实验,一般是向实验动物注射人源肿瘤使其成瘤,通过观察瘤体生长来判断肿瘤的生物学变化。如图所示,根据动物体内肿瘤大小来进行后续分析。
肿瘤细胞增殖是一个复杂而神秘的过程,它既是生命的挑战,也是医学研究的希望。通过不断深入的研究,我们相信在未来,我们将能够更好地理解肿瘤细胞增殖的机制,开发出更有效的诊断和治疗方法,为人类的健康带来新的曙光。
























 被折叠的 条评论
为什么被折叠?
被折叠的 条评论
为什么被折叠?








